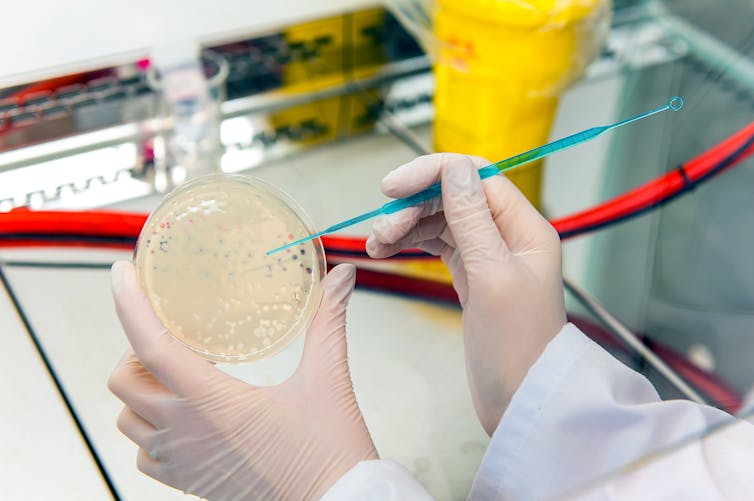

Las vacunas de COVID-19 no pueden contagiarle el cáncer
Javier Cantón, Campus Internacional para la Seguridad y Defensa (CISDE)
La aparición de vacunas frente a la COVID-19 ha suscitado esperanza e inquietud por su rapidez. Como producto médico, no cabe duda que han revolucionado la medicina y salvado millones de vidas desde su utilización en los últimos siglos. Y, aunque las desarrolladas contra el coronavirus SARS-CoV-2 ya han empezado a mostrar sus beneficios, tampoco se han librado de decenas de bulos ya desmentidos.
La última noticia falsa acerca de estas vacunas tiene que ver con el posible desarrollo de cáncer por parte de quienes sean inoculados con aquellas que usan células en sus procesos de fabricación, como la de AstraZeneca o Janssen. Estas críticas infundadas no son nuevas.
Estas vacunas tienen mala fama entre los colectivos antivacunas desde antes de que apareciese el SARS-CoV-2. En este artículo intentaremos aportar un poco de luz a esta cuestión y veremos que no hay base científica para hacer tales afirmaciones.
Los virus no pueden replicarse por sí mismos: necesitan una célula que infectar y de cuya maquinaria apropiarse para ponerla a trabajar. Por esta razón, las vacunas de Janssen, AstraZeneca y Sputnik V, basadas en adenovirus modificados genéticamente que expresen la proteína S del SARS-CoV-2, requieren la utilización de células.

En los laboratorios se suelen utilizar líneas celulares que pueden dividirse de forma ilimitada, es decir, que son cancerígenas. De hecho, muchas provienen de tumores humanos. Sin embargo, la probabilidad de generar cáncer por esta vía es prácticamente nula. Por un lado, debido a la cantidad y estado de restos celulares en un vial. Por otro lado, por la ausencia del carácter contagioso de un tumor en seres humanos.
Respecto al primer punto, según datos declarados por la propia farmacéutica, cada vial de la vacuna de Janssen podría contener un máximo de 3 nanogramos (0,000000003 gramos) de ADN proveniente de las células en las que se fabrican estas vacunas. Esto ha llamado la atención de algunos escépticos, que lo han incluido en su argumentario antivacunas bajo la amenaza de que “la vacuna puede originarte un tumor”.

Hay dos razones principales por las que ese riesgo es despreciable. Por un lado, la estabilidad del ADN proveniente de las células se pierde durante los procesos de filtración y purificación de las vacunas. El ADN que puede superar dichos procesos es una cantidad ínfima y estaría altamente fragmentado.
La otra razón es que dicho ADN celular tendría serias dificultades para integrarse en nuestro propio ADN e introducir genes precursores de cáncer (u oncogenes). No es nada fácil conseguir que ese paso ocurra. De hecho, si fuera así de fácil, la terapia génica habría avanzado enormemente en estos años. La realidad es que hacen falta proteínas específicas que nuestras células no tienen, como las del virus del sida, o utilizar el sistema de edición genética CRISPR-Cas9.
Todos los estudios respaldan la seguridad de usar células
Con todo, existen varios artículos científicos que respaldan el uso y seguridad de líneas celulares para la generación de vacunas. El organismo regulador de fármacos en Estados Unidos, la FDA, establece el límite en 10 nanogramos de ADN celular, por lo que los 3 ng de ADN en vacuna de Janssen están dentro del margen de confianza. Además, teniendo en cuenta lo fragmentado que llega ese ADN, sería posible admitir cantidades superiores, según se indica en este estudio.
En otro artículo científico se evalúan precisamente las células que usa Janssen para su vacuna, de la línea celular PER.C6. Se demostró la seguridad de los protocolos de fabricación de vacunas basadas en adenovirus, como la de Janssen, en células tumorales humanas. Confirmaron que las trazas celulares no eran capaces de generar tumores.
De hecho, se han elaborado modelos matemáticos para calcular la probabilidad de desarrollar un cáncer por culpa de esas trazas de ADN. Se estima que haría falta poner 230 000 000 000 vacunas para que apareciese un cáncer producido por inserción de oncogenes de las células fabricantes de vacunas dentro de una de nuestras células. Es decir, tendríamos que vacunar a la población mundial 32 veces antes de ver ese efecto.

El cáncer no se contagia en seres humanos
También habría que tener en cuenta que, aunque en animales del grupo de los moluscos sí se han visto cánceres contagiosos, el cáncer no lo es para los seres humanos. Ello se debe, en parte, a que nuestro sistema inmunitario se encarga de controlar que el crecimiento de las células no se descontrole. En algunos trasplantes de órganos se puede generar cáncer, pero es debido a que la cantidad de células ajenas recibidas es inmensamente mayor y, además, los pacientes reciben fármacos inmunosupresores para tolerar el nuevo órgano.
Cuando hablamos de agentes infecciosos cancerígenos solemos referirnos a virus que causan cáncer. Ejemplos de ellos son el del papiloma humano o el virus Epstein-Barr, entre otros. Pero las células utilizadas para la fabricación de adenovirus modificados genéticamente por sí mismas no son capaces, como hemos mencionado, de inducir la aparición de cáncer.
La realidad es que llevamos décadas utilizando vacunas generadas en células tumorales sin que se haya visto una correlación entre personas vacunadas y aparición de tumores. Ejemplos de ellas son las vacunas frente a la rubéola o al sarampión. Se administran millones de vacunas todos los años sin que se haya visto un efecto oncogénico. De nuevo, sigue siendo muchísimo más seguro vacunarse que no vacunarse.